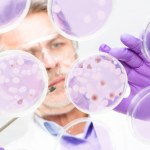
Ukryta supermoc ziemskich mikroorganizmów. Naukowcy to zbadali

plastik
- Wszystkie (62)
- Wiadomości (62)
Wiadomości (62)
-
Słońce zmienia plastikowe śmieci w czysty wodór. Rewolucja w ekotechnologii
- Piątek, 15 maja (19:26)
-
Plastikowe butelki znikną tuż po wypiciu płynu. Koniec z segregowaniem
- Poniedziałek, 11 maja (18:45)
Chińczycy stworzyli pierwszy "żywy plastik", który po opróżnieniu może rozłożyć się całkowicie bez powstawania mikroplastików. W materiał wbudowane są zarodniki bakterii, które aktywują...ekologia, plastik -
Nowy biodegradowalny plastik. Rewolucja w walce z mikroplastikiem
- Poniedziałek, 4 maja (18:36)
-
Ukryta supermoc ziemskich mikroorganizmów. Naukowcy to zbadali
- Niedziela, 19 kwietnia (19:20)
-
Czy odpady plastikowe staną się cennym surowcem? To przełom według badaczy
- Wtorek, 10 marca (07:20)